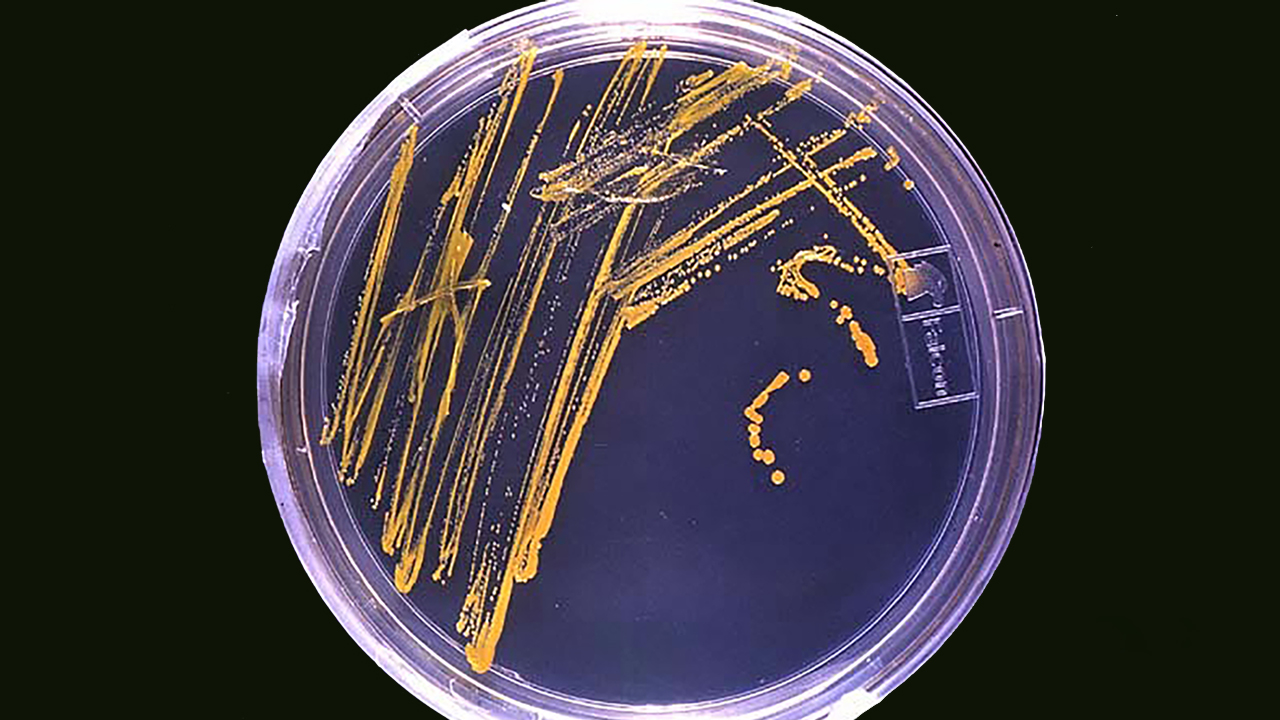

Staphylococcus в кале
Саженцы абрикосов из косточки
Мардан 07.08 2025
Сборник по егэ английский язык
Университет им мечникова отзывы
Машинка на которой ребенок катается
Орксэ светская этика рабочая программа фгос
Гисметео камское
Какое пожелание можно сказать
Квартиры от собственников в терновке пенза
Поздравить с ореховым спасом картинки
16 25.4
В порядке ростов
Scp secret laboratory сколько scp
Staphylococcus в кале 117 фотографий